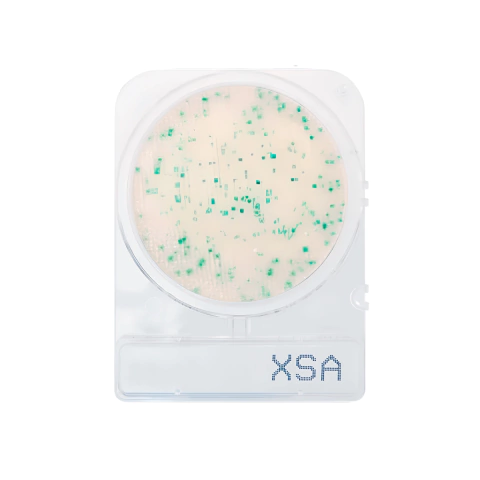
Compact Dry X-SA Staphylococcus Aureus (4 Unidades)

FRETE GRÁTIS PARA REGIÃO DE CAMPINAS EM PEDIDOS ACIMA DE R$100,00
FRETE GRÁTIS PARA SUL E SUDESTE EM COMPRAS ACIMA DE R$1500,00


-
Plásticos
- Almotolia
- Balão Volumétrico
- Balde Graduado
- Bandeja de Plástico
- Barril
- Bastão Agitador de Plástico
- Becker de Polipropileno (Forma Baixa)
- Becker de PTFE
- Bombona
- Borrifador
- Cone de Imhoff
- Frasco Erlenmeyer
- Espátula e Colher de Plástico
- Estante (Rack) de Plástico
- Funil de Plástico
- Frasco de Plástico
- Jarra de Plástico
- Microtubo
- Pegador Magnético
- Pisseta
- Ponteira para Micropipeta
- Pipeta Pasteur
- Pipeta Sorológica
- Proveta de Plástico
- Tubo de Ensaio de Plástico
- Tubo para Centrífuga (Falcon)
- Vidro de Relógio
- Outros Plásticos
- Acidímetro de Dornic
- Caixa Organizadora
- Coletor de Amostras
- Suporte para Butirômetros
- Disco de Lentine
- Concha de Cereais
- Repipetador em Polipropileno
- Rack
- Célula Vegetal
- Célula Animal
- Cálice de Plástico
-
Acessórios
- Alonga de Borracha
- Barra Magnética
- Caixa Porta Lâminas
- Cesto para Transporte
- Coluna de Cromatografia
- Copo Ford
- Cubeta
- Equipamentos de Proteção Individual (EPI)
- Escorredor de Vidrarias
- Escova para Limpeza
- Espátulas
- Hastes e Hélices
- Lâmpadas
- Mangueira
- Mesa Antivibratória
- Pêra Insufladora
- Pinça de Madeira
- Pipetador de Borracha
- Pipetador (Pi-Pump)
- Rolhas e Tampas
- Sensor
- Suporte Universal
- Suporte para Cone
- Suporte para Cuba de Coloração
- Suporte para Buretas
- Suporte para Butirômetro
- Suporte para Densímetros
- Suporte para Funis
- Suporte para Lâminas
- Suporte para Micropipetas
- Suporte para Pipetas
- Suporte para Tubos
- Suporte para Termômetro
- Outros Acessórios
-
Consumíveis
- Algodão
- Alça e Espalhador
- Avental Descartável
- Barquinha de Pesagem
- Câmara de Contagem
- Esparadrapo
- Fita Adesiva Hospitalar
- Fita Medidora de pH
- Fita para Autoclave
- Filtro para Seringa
- Frascos Consumíveis
- Gaze
- Lâmina e Lamínula
- Luva Descartável
- Máscara Descartável
- Membrana Filtrante
- Navalha Descartável
- Papel Filtro
- Papel Grau Cirúrgico
- Placa de Petri
- Parafilm M
- Pavio para Lamparina
- Saco para Autoclave
- Sapatilha Descartável
- Seringa Descartável
- Swab
- Touca Descartável
- Outros Consumíveis
- Descontos
-
Equipamentos
- Agitador Magnético
- Agitador de Kline
- Agitador Mecânico
- Agitador de Tubos Vortex
- Agitador Jar Test
- Autoclave
- Balança
- Banho Maria
- Banho Ultrassônico
- Bomba de Vácuo
- Bureta Digital
- Câmara Escura
- Capela para Exaustão
- Carrinho
- Centrífuga
- Contador de Colônias
- Chapa Aquecedora
- Chuveiro e Lava Olhos
- Deionizador de Água
- Dispensador de Líquidos
- Eletrodo para pHmetro
- Espectrofotômetro
- Estufa
- Lavador de Pipetas
- Manta Aquecedora
- Medidor de pH (pHmêtro)
- Microscópio
- Viscosímetro Rotacional
- Outros Equipamentos
-
Inox e Ferragens
- Anel de Aço Inox
- Anel de Ferro
- Cabo de Kolle
- Cadinho em Inox
- Bandeja para Coloração
- Balde de Inox
- Berço em Aço Inox
- Bico de Bunsen
- Espátula com Colher em Aço Inox
- Espátula em Arame de Aço Inox
- Espátula em Aço Inox com Cabo
- Estante em Arame de Aço Inox
- Estante em Arame de Ferro Zincado
- Estante em Arame Revestida de PVC
- Estante para Tubos
- Estojo em Aço Inox
- Fio de Níquel
- Funil de Inox
- Furador de Rolhas
- Garrafa Saca Amostra
- Molde de Inclusão
- Mufa Dupla
- Peneira Granulométrica
- Peso Padrão em Inox
- Pinça Monjonier
- Pinça para Bureta
- Pinça para Cadinho
- Pinça para Cápsula
- Pinça para Caçarola
- Pinça para Copo
- Pinça para Condensador
- Pinça para Frascos
- Pinça para Termômetro
- Pinça para Tubo de Ensaio
- Placa de Petri
- Plataforma Tipo Jack
- Tela de Arame com Refratário
- Tripé de Ferro
- Sistema de Filtração a Vácuo (Inox)
- Suporte Universal
- Suporte
- Outras Pinças
- Outros Inox e Ferragens
- Instrumentos
- Kits
- Porcelanas
- Produtos Estudantis
- Reagentes e Meios de Cultura
-
Vidrarias
- Acidímetro de Dornic
- Balão de Destilação
- Balão Fundo Chato
- Balão Fundo Redondo
- Balão Volumétrico
- Balão para Rotaevaporação
- Bastão Agitador de Vidro
- Becker de Vidro (Forma Alta)
- Becker de Vidro (Forma Baixa)
- Bureta Graduada
- Butirômetro
- Cadinho de Vidro
- Cálice de Vidro
- Copo Shop Rigler
- Condensador
- Conexões de Vidro
- Cristalizador
- Cuba de Coloração
- Dean Stark
- Dessecador de Vidro
- Funil de Vidro
- Frasco B.O.D
- Frasco Conta-Gotas
- Frasco Diluição de Leite
- Frasco Erlenmeyer
- Frasco Índice de Iodo
- Frasco Kitazato
- Frasco Mariotte
- Frasco para Bureta
- Frasco Pluma
- Frasco Reagente
- Gral com Pistilo
- Lamparina de Vidro
- Picnômetro
- Pipeta Graduada/Volumétrica
- Pipeta Kipp
- Pipeta Sorológica
- Placa de Petri
- Proveta de Vidro
- Seringa de Vidro
- Vials e Tampas
- Vidro de Relógio
- Tubo Capilar
- Tubo Centrífuga
- Tubo de Duran
- Tubo de Ensaio
- Tubo Nessler
- Tubo para Bloco Digestor
- Vidrarias Especiais
- Bastões de Vidro
- Rastreio
-
- Agitador Magnético
- Agitador de Kline
- Agitador Mecânico
- Agitador de Tubos Vortex
- Agitador Jar Test
- Autoclave
- Balança
- Banho Maria
- Banho Ultrassônico
- Bomba de Vácuo
- Bureta Digital
- Câmara Escura
- Capela para Exaustão
- Carrinho
- Centrífuga
- Contador de Colônias
- Chapa Aquecedora
- Chuveiro e Lava Olhos
- Deionizador de Água
- Dispensador de Líquidos
- Eletrodo para pHmetro
- Espectrofotômetro
- Estufa
- Lavador de Pipetas
- Manta Aquecedora
- Medidor de pH (pHmêtro)
- Microscópio
- Viscosímetro Rotacional
- Outros Equipamentos
-
- Acidímetro de Dornic
- Balão de Destilação
- Balão Fundo Chato
- Balão Fundo Redondo
- Balão Volumétrico
- Balão para Rotaevaporação
- Bastão Agitador de Vidro
- Becker de Vidro (Forma Alta)
- Becker de Vidro (Forma Baixa)
- Bureta Graduada
- Butirômetro
- Cadinho de Vidro
- Cálice de Vidro
- Copo Shop Rigler
- Condensador
- Conexões de Vidro
- Cristalizador
- Cuba de Coloração
- Dean Stark
- Dessecador de Vidro
- Funil de Vidro
- Frasco B.O.D
- Frasco Conta-Gotas
- Frasco Diluição de Leite
- Frasco Erlenmeyer
- Frasco Índice de Iodo
- Frasco Kitazato
- Frasco Mariotte
- Frasco para Bureta
- Frasco Pluma
- Frasco Reagente
- Gral com Pistilo
- Lamparina de Vidro
- Picnômetro
- Pipeta Graduada/Volumétrica
- Pipeta Kipp
- Pipeta Sorológica
- Placa de Petri
- Proveta de Vidro
- Seringa de Vidro
- Vials e Tampas
- Vidro de Relógio
- Tubo Capilar
- Tubo Centrífuga
- Tubo de Duran
- Tubo de Ensaio
- Tubo Nessler
- Tubo para Bloco Digestor
- Vidrarias Especiais
- Bastões de Vidro
-
- Alonga de Borracha
- Barra Magnética
- Caixa Porta Lâminas
- Cesto para Transporte
- Coluna de Cromatografia
- Copo Ford
- Cubeta
- Equipamentos de Proteção Individual (EPI)
- Escorredor de Vidrarias
- Escova para Limpeza
- Espátulas
- Hastes e Hélices
- Lâmpadas
- Mangueira
- Mesa Antivibratória
- Pêra Insufladora
- Pinça de Madeira
- Pipetador de Borracha
- Pipetador (Pi-Pump)
- Rolhas e Tampas
- Sensor
- Suporte Universal
- Suporte para Cone
- Suporte para Cuba de Coloração
- Suporte para Buretas
- Suporte para Butirômetro
- Suporte para Densímetros
- Suporte para Funis
- Suporte para Lâminas
- Suporte para Micropipetas
- Suporte para Pipetas
- Suporte para Tubos
- Suporte para Termômetro
- Outros Acessórios
-
- Almotolia
- Balão Volumétrico
- Balde Graduado
- Bandeja de Plástico
- Barril
- Bastão Agitador de Plástico
- Becker de Polipropileno (Forma Baixa)
- Becker de PTFE
- Bombona
- Borrifador
- Cone de Imhoff
- Frasco Erlenmeyer
- Espátula e Colher de Plástico
- Estante (Rack) de Plástico
- Funil de Plástico
- Frasco de Plástico
- Jarra de Plástico
- Microtubo
- Pegador Magnético
- Pisseta
- Ponteira para Micropipeta
- Pipeta Pasteur
- Pipeta Sorológica
- Proveta de Plástico
- Tubo de Ensaio de Plástico
- Tubo para Centrífuga (Falcon)
- Vidro de Relógio
- Outros Plásticos
- Acidímetro de Dornic
- Caixa Organizadora
- Coletor de Amostras
- Suporte para Butirômetros
- Disco de Lentine
- Concha de Cereais
- Repipetador em Polipropileno
- Rack
- Célula Vegetal
- Célula Animal
- Cálice de Plástico
-
- Algodão
- Alça e Espalhador
- Avental Descartável
- Barquinha de Pesagem
- Câmara de Contagem
- Esparadrapo
- Fita Adesiva Hospitalar
- Fita Medidora de pH
- Fita para Autoclave
- Filtro para Seringa
- Frascos Consumíveis
- Gaze
- Lâmina e Lamínula
- Luva Descartável
- Máscara Descartável
- Membrana Filtrante
- Navalha Descartável
- Papel Filtro
- Papel Grau Cirúrgico
- Placa de Petri
- Parafilm M
- Pavio para Lamparina
- Saco para Autoclave
- Sapatilha Descartável
- Seringa Descartável
- Swab
- Touca Descartável
- Outros Consumíveis
-
- Anel de Aço Inox
- Anel de Ferro
- Cabo de Kolle
- Cadinho em Inox
- Bandeja para Coloração
- Balde de Inox
- Berço em Aço Inox
- Bico de Bunsen
- Espátula com Colher em Aço Inox
- Espátula em Arame de Aço Inox
- Espátula em Aço Inox com Cabo
- Estante em Arame de Aço Inox
- Estante em Arame de Ferro Zincado
- Estante em Arame Revestida de PVC
- Estante para Tubos
- Estojo em Aço Inox
- Fio de Níquel
- Funil de Inox
- Furador de Rolhas
- Garrafa Saca Amostra
- Molde de Inclusão
- Mufa Dupla
- Peneira Granulométrica
- Peso Padrão em Inox
- Pinça Monjonier
- Pinça para Bureta
- Pinça para Cadinho
- Pinça para Cápsula
- Pinça para Caçarola
- Pinça para Copo
- Pinça para Condensador
- Pinça para Frascos
- Pinça para Termômetro
- Pinça para Tubo de Ensaio
- Placa de Petri
- Plataforma Tipo Jack
- Tela de Arame com Refratário
- Tripé de Ferro
- Sistema de Filtração a Vácuo (Inox)
- Suporte Universal
- Suporte
- Outras Pinças
- Outros Inox e Ferragens
-
- Orçamentos

 Estados Unidos
Estados Unidos